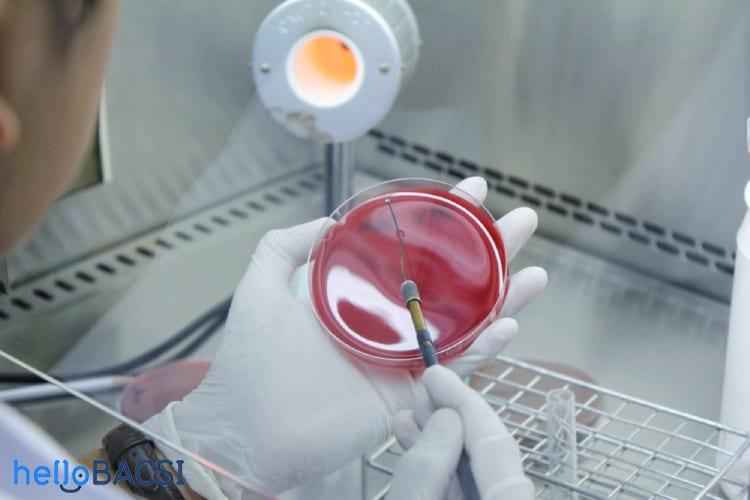
Cấy đờm

Đờm (hay đàm) là chất nhầy được tiết ra từ các tế bào ở đường hô hấp dưới. Nó có thể chứa cả chất lạ được hít vào phổi, tế bào miễn dịch hay các tế bào bạch cầu. Chất nhầy này có tác dụng bẫy vật lạ để lông mao ở trong đường thở làm sạch và tống ra khỏi phổi. Bên cạnh đó, đờm cũng chứa các tế bào miễn dịch nhằm tiêu diệt vi khuẩn để chúng không thể tồn tại trong phổi và gây nhiễm trùng.
Trường hợp nhiễm trùng, trong đờm sẽ xuất hiện vi khuẩn. Khi bị ung thư phổi, chấn thương đường hô hấp, tổn thương đường thở hoặc phù phổi, người bệnh còn có máu trong đờm.
Cấy đờm là phương pháp phân tích đờm được thực hiện trong phòng thí nghiệm nhằm đánh giá tình trạng nhiễm trùng hoặc tìm kiếm dấu hiệu của ung thư. Một chất thúc đẩy sự phát triển của vi khuẩn sẽ được thêm vào mẫu đờm.
Nếu không có vi khuẩn, kết quả nuôi cấy là âm tính, ngược lại là dương tính. Loại vi khuẩn có thể được xác định bằng kính hiển vi hoặc xét nghiệm hóa học. Khi xác định được nguyên nhân gây ra những triệu chứng (xem phần tiếp theo) của người bệnh, bác sĩ sẽ có hướng điều trị tốt nhất. Cấy đờm có ý nghĩa quan trọng trong việc quyết định lựa chọn loại kháng sinh phù hợp.
Cấy đờm được chỉ định trong các trường hợp viêm nhiễm đường hô hấp dưới như viêm phổi, viêm phế quản cấp, các cơn cấp của viêm phế quản mạn tính, bệnh lao, áp xe phổi.
Ngoài ra khi gặp các triệu chứng sau, người bệnh cũng có thể được chỉ định thực hiện xét nghiệm cấy đờm:
Cần thực hiện cấy đờm ở giai đoạn sớm của bệnh càng tốt (ngay sau khi có chẩn đoán lâm sàng) và trước khi người bệnh dùng kháng sinh.
Để thực hiện cấy đờm, bác sĩ sẽ cần thu thập mẫu đờm. Do đó, cổ họng có thể cảm thấy đau sau khi ho khạc, nội soi phế quản hoặc lấy mẫu đờm bằng ống thông mũi họng. Nếu bị hen suyễn nặng hoặc viêm phế quản, người bệnh có thể thấy khó thở trong quá trình lấy mẫu.
Trong trường hợp được dùng thuốc tê, người bệnh có thể cảm thấy như lưỡi và cổ họng bị sưng, khó nuốt. Nếu người bệnh vừa phẫu thuật ở ổ bụng, bác sĩ có thể hướng dẫn giảm thiểu sự khó chịu bằng cách đặt một chiếc gối lên trên bụng và giữ chặt. Nhìn chung, không có rủi ro đặc biệt nguy hiểm nào khi thực hiện cấy đờm. Người bệnh chỉ cần thư giãn, thả lỏng và hít thở đều.
Những thông tin được cung cấp không thể thay thế cho lời khuyên của các chuyên viên y tế. Hãy luôn tham khảo ý kiến bác sĩ.
Hầu hết trường hợp, mẫu đờm được thu thập vào sáng sớm. Người bệnh có thể được yêu cầu không ăn uống hay sử dụng bất kỳ loại kháng sinh nào. Người bệnh cần uống nhiều nước nhằm làm loãng dịch tiết, giúp ho ra đờm dễ dàng hơn. Nếu có đeo răng giả, người bệnh cần phải tháo ra. Bác sĩ có thể yêu cầu súc miệng bằng nước sạch để loại bỏ các vi khuẩn cũng như nước bọt. Tùy trường hợp (chẳng hạn như bệnh lao), người bệnh có thể cần lấy ít nhất là 3 mẫu đờm trong 3 ngày liên tục.
Sau khi thực hiện các bước chuẩn bị như trên, người bệnh cần hít một hơi thật sâu và ho mạnh để lấy được mẫu đờm. Người bệnh sẽ được yêu cầu nhổ đờm vào lọ vô trùng có nắp, tránh lẫn nước bọt. Phải cẩn thận trong quy trình lấy mẫu để đảm bảo mẫu được lấy từ đường hô hấp dưới, không phải đường hô hấp trên.
Một lần thực hiện cấy đờm sẽ cần ít nhất 2ml đờm để xét nghiệm. Nếu gặp khó khăn trong việc ho, bác sĩ có thể hỗ trợ bằng cách vỗ vào lưng người bệnh hoặc cho hít khí dung vô trùng, glycerin aerosol trong vài phút để làm lỏng đờm trong phổi.
Ngoài ra còn có những phương pháp khác giúp lấy mẫu bệnh phẩm là:
Mẫu đờm được đậy nắp chặt và gửi ngay đến phòng thí nghiệm. Nếu vì một lý do gì đó chưa thể thực hiện xét nghiệm được, mẫu đờm có thể giữ trong tủ lạnh nhưng không quá 2 giờ.
Tất cả các mẫu đờm sau khi đánh giá đủ độ tin cậy thì tiến hành nuôi cấy ngay. Các mẫu không đạt tiêu chuẩn thì người bệnh cần phải lấy mẫu lại. Riêng các mẫu lẫn nước bọt hoặc có độ tin cậy vừa phải, nhân viên y tế vẫn có thể yêu cầu lấy mẫu lại hoặc tiếp tục tiến hành nuôi cấy nhưng phải cố lấy mầm cấy là vùng đờm mủ, tránh lấy nhớt hay nước bọt.
Mẫu đờm đạt yêu cầu sẽ được đặt trong một đĩa chứa có môi trường nuôi cấy vi khuẩn, giúp vi khuẩn hoặc nấm phát triển. Thời gian để vi khuẩn phát triển là trong 2–3 ngày. Nấm thường mất 1 tuần hoặc lâu hơn. Các sinh vật gây bệnh lao có thể cần đến 6 tuần để phát triển. Bất kỳ dấu hiệu nào cho thấy vi khuẩn hoặc nấm phát triển sẽ được quan sát dưới kính hiển vi hoặc bằng các xét nghiệm hóa học. Phân tích độ nhạy của kháng sinh cũng được tiến hành nhằm tìm ra loại kháng sinh tốt nhất và thường mất thêm 1–2 ngày nữa.
Với nhiễm trùng đường hô hấp do vi khuẩn, đờm có thể có độ đặc sệt (nhớt), bị đổi màu, có thể có máu và mùi khó chịu. Cụ thể là:
Cấy đờm tìm vi khuẩn sẽ cho ra 2 loại kết quả.
Cần lưu ý rằng một số vi khuẩn phát triển tự nhiên trong đường thở mà không gây bệnh. Kết quả cấy đờm sẽ giúp phân biệt chúng với loại vi khuẩn gây bệnh, từ đó chọn được loại kháng sinh tốt nhất cho người bệnh.
Nếu bạn có bất kỳ câu hỏi nào, hãy tham khảo ý kiến bác sĩ để được tư vấn phương pháp hỗ trợ điều trị tốt nhất.
Hello Bacsi không đưa ra các lời khuyên, chẩn đoán hay các phương pháp điều trị y khoa.
Closing message display
Hello Bac Si is committed to supporting your health journey by providing reliable, evidence-based health information. Please note:
This content is for reference purposes only and does not replace professional medical advice.
Individual health conditions may vary, so we strongly encourage consulting a qualified healthcare professional for personalized guidance.
Learn more about our mission and medical review process at Hello Bac Si
This content is for reference purposes only and does not replace professional medical advice.
Individual health conditions may vary, so we strongly encourage consulting a qualified healthcare professional for personalized guidance.
Miễn trừ trách nhiệm
Các bài viết của Hello Bacsi chỉ có tính chất tham khảo, không thay thế cho việc chẩn đoán hoặc điều trị y khoa.
What Is a Sputum Culture? https://www.webmd.com/lung/what-is-a-sputum-culture Ngày truy cập 6/1/2020
Routine Sputum Culture. https://www.healthline.com/health/routine-sputum-culture Ngày truy cập 6/1/2020
Sputum Culture. https://www.labtestsonline.org.au/learning/test-index/sputum-culture Ngày truy cập 6/1/2020
Phiên bản hiện tại
24/03/2020
Tác giả: Ngà Trương
Tham vấn y khoa: Bác sĩ Nguyễn Thường Hanh
Cập nhật bởi: Bác sĩ Nguyễn Thường Hanh
Tham vấn y khoa:
Bác sĩ Nguyễn Thường Hanh
Nội khoa - Nội tổng quát · Bệnh Viện Đa Khoa Tỉnh Bắc Ninh